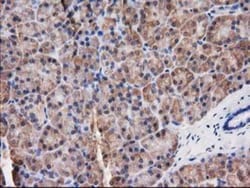
Destrin Antibody (OTI2F7), Novus Biologicals 0.1mL; Unlabeled:Antibodies,

Promotional price valid on web orders only. Your contract pricing may differ. Interested in signing up for a dedicated account number?
Learn More
Learn More
Destrin Antibody (OTI2F7), Novus Biologicals™


Mouse Monoclonal Antibody
Supplier: Novus Biologicals NBP200527
Description
Destrin Monoclonal specifically detects Destrin in Human, Mouse, Canine, Primate, Monkey samples. It is validated for Western Blot, Flow Cytometry, Immunohistochemistry, Immunocytochemistry/Immunofluorescence, Immunohistochemistry-Paraffin.Specifications
| Destrin | |
| Monoclonal | |
| 0.4 mg/mL | |
| Western Blot 1:500-2000, Flow Cytometry 1:100, Immunohistochemistry 1:10-1:500, Immunocytochemistry/Immunofluorescence 1:100, Immunohistochemistry-Paraffin 1:150 | |
| DSTN | |
| Full length human recombinant protein of human DSTN (NP_006861) produced in HEK293T cell. | |
| Affinity Purified | |
| RUO | |
| 11034 | |
| Store at -20°C. Avoid freeze-thaw cycles. |
| Western Blot, Flow Cytometry, Immunohistochemistry, Immunocytochemistry, Immunofluorescence, Immunohistochemistry (Paraffin) | |
| OTI2F7 | |
| Unconjugated | |
| ACTDPdestrin, Actin-depolymerizing factor, ADFbA462D18.2 (destrin (actin depolymerizing factor ADF) (ACTDP)), bA462D18.2, destrin (actin depolymerizing factor), DSN | |
| Mouse | |
| 18.3 kDa | |
| 0.1 mL | |
| Primary | |
| Human, Mouse, Canine, Primate, Monkey | |
| IgG1 |
Product Content Correction
Your input is important to us. Please complete this form to provide feedback related to the content on this product.
Product Title
For Research Use Only
Spot an opportunity for improvement?Share a Content Correction